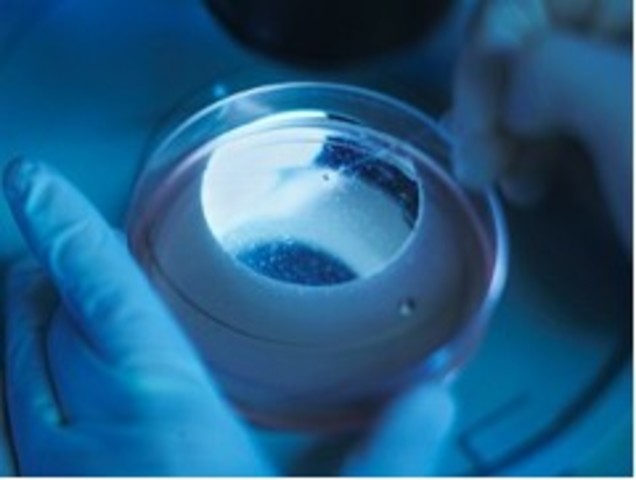
Stem Cell Research Laboratory Breakthroughs and Some Clinical Advances

-
-
the first pharmacy was made
-
-
-
-
people first started using eye glasses
-
-
-
First full body map by Leonardo Da Vinci
-
-
-
-
The French ophthalmologist Jacques Daviel (1696–1762) was the first modern European physician to successfully extract cataracts from the eye. He performed the first extracapsular cataract extraction on April 8, 1747. It was the first significant advance in cataract surgery since couching was invented.
-
-
-
-
-
-
On this date in 1893, the first successful American open-heart surgery was performed by a Black surgeon, Dr. Daniel Hale Williams. Dr. Daniel Williams completed the operation on a young man named James Cornish.
-
-
The Band-Aid was invented in 1920 by Thomas Anderson and Johnson & Johnson employee Earle Dickson in Escondido, California for his wife Josephine, who frequently cut and burned herself while cooking. The prototype allowed her to dress her wounds without assistance.
-
-
-
-
-
-
-
-
-
he studied hes patients.
A list shows items. A timeline shows sequence.
Use Timetoast to make dates, milestones, and turning points easier to understand in a clear visual format. Timetoast is a timeline maker for work, school, research, and stories.